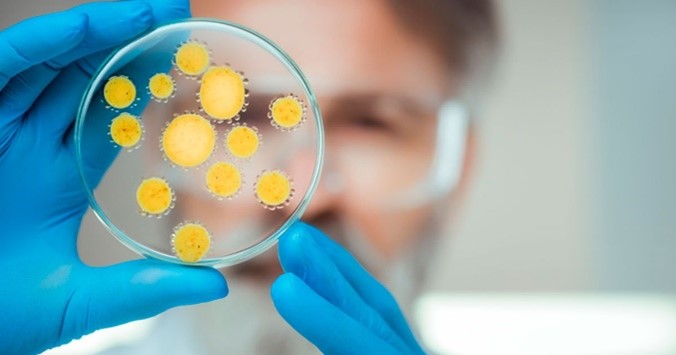

ASSINTOMÁTICOS

Na literatura médica, sintoma é qualquer alteração da percepção normal que uma pessoa tem de seu próprio corpo, do seu metabolismo, de suas sensações, podendo ou não se consistir em um início de doença.
A palavra vírus vem do latim “virus”, que significa fluído venenoso ou toxina. Os vírus são seres muito simples e pequenos, formados basicamente por uma cápsula proteica envolvendo o material genético, que, dependendo do tipo de vírus, pode ser o DNA, RNA ou os dois juntos.


Derivado do latim “bene” = “bem” e “-genus” = “nascido”, é um termo médico usado para descrever doenças leves e não progressivas. O termo é mais conhecido como uma descrição de neoplasias não cancerosas, mas também pode se referir a outras condições. Significa “não faz danos à saúde”.

É uma doença crônica em que a pressão arterial está sempre elevada. A doença geralmente não causa sintomas. No entanto, a longo prazo, é um dos principais fatores de risco para muitas doenças graves como: Aterosclerose coronariana; AVC; Insuficiência cardíaca; Doença arterial periférica; Perda da visão; Insuficiência renal crônica e Demência.

É um distúrbio no nível de lipídios e/ou lipoproteínas no sangue. Os lipídios (moléculas de gordura) são transportados em uma cápsula de proteína, e a densidade lipídica e o tipo de proteína determinam o destino da molécula e seu efeito no metabolismo.
CORONAVÍRUS

O coronavírus é uma grande família de vírus comuns em muitas espécies diferentes de animais, incluindo camelos, gado, gatos e morcegos.
É uma doença causada pelo coronavírus, que apresenta um espectro clínico variando de infecções assintomáticas a quadros graves. De acordo com a Organização Mundial de Saúde, a maioria (cerca de 80%) dos pacientes com COVID-19 podem ser assintomáticos ou oligossintomáticos, e aproximadamente 20% dos casos detectados requer atendimento hospitalar por apresentarem dificuldade respiratória.

Refere-se aquele que encontra-se como portador de um vírus em seu sistema imunológico. A pessoa infectada pode apresentar sintomas ou não, depende da reação de cada organismo diante do que o paciente contraiu. No que diz respeito ao coronavírus, no momento, temos 33.785.178 infectados no mundo, 23.448.934 casos recuperados e 1.010.147 de mortes, sendo 4.810.935 casos no Brasil, 4.180.376 de casos recuperados e 143.952 de mortes no Brasil por coronavírus

Esse tipo de termo é utilizado quando algum assunto se torna algo populoso, várias pessoas sabem do assunto falado. No caso da COVID-19 diz respeito à forma de contágio entre as pessoas em um curto espaço de tempo. Sabe-se que dependendo do período de incubação do vírus pode-se imaginar o nível de contaminação. As pessoas podem pegar a COVID-19 de outras que têm o vírus. A doença pode ser transmitida, principalmente, de pessoa para pessoa por meio de gotículas do nariz ou da boca que se espalham quando uma pessoa com COVID-19 tosse, espirra ou fala. Essas gotículas são relativamente pesadas, não viajam longe e caem rapidamente no chão. Podem, no entanto, pegar a COVID-19 se respirarem essas gotículas de uma pessoa infectada pelo vírus. É por isso que é importante ficar pelo menos a 1 metro de distância dos outros.
O termo em evidência nunca foi tão usado como tem sido no atual momento. Isso porque a grande polêmica que gira em torno dessa palavra está ligada à transmissão ou não do vírus da COVID-19, ou seja, uma pessoa sem sintoma pode transmitir a doença de forma silenciosa, segundo os médicos infectologistas. O Coronavírus assintomático é muito mais comum do que parece e acontece em dois terços das pessoas infectadas, segundo um estudo realizado pela revista Science.
Enquanto algumas pessoas sentem os primeiros sintomas, outras não chegam sequer a saber que estavam doentes. Segundo a OMS, pacientes assintomáticos também podem transmitir o Coronavírus, embora a

Transmissão é a passagem de um vírus, por exemplo, de uma pessoa doente para uma pessoa saudável. A principal maneira pela qual a doença se espalha é através de gotículas respiratórias expelidas por alguém que está tossindo ou tem outros sintomas, como febre e cansaço. Muitas pessoas com COVID-19 experimentam apenas sintomas leves, particularmente nos estágios iniciais da doença. É possível pegar COVID-19 de alguém com tosse leve e que não se sente doente. Alguns relatórios indicaram que pessoas sem sintomas podem transmitir o vírus. Ainda não se sabe com que frequência isso acontece.

Máscara é o elemento usado para cobrir o rosto total ou parcialmente, exemplos de máscaras são para festas e eventos, ou para procedimentos médicos, como cirurgias, por exemplo. Cirúrgicas; descartáveis; laváveis; tipo bico de papagaio; caseiras; de pano; estilo bandana; com lenço tradicionalista; com filtro de papel; com a frente transparente para a expressão dos lábios; estampando o brasão do time do coração ou a marca dos personagens favoritos; elas surgiram nas ruas de todos os modos.
Sem elas, não se pode entrar em estabelecimentos, nem usar o transporte coletivo, tampouco ser cidadão novamente. Em muitos lugares, as máscaras faciais já são obrigatórias, e sua ausência pode ser motivo de sanção.
SÃO RESPONSÁVEIS PELA TRANSMISSÃO DO VÍRUS
As pessoas infectadas com COVID-19 que não apresentam sintomas, as chamadas assintomáticas, são provavelmente as principais responsáveis pela manutenção da cadeia de reprodução do vírus na sociedade. Essa ideia de que um assintomático é responsável pela transmissão do vírus vem do médico
A pandemia causada pelo coronavírus trouxe à tona o trabalho de um profissional com uma especialidade médica pouco conhecida: a do infectologista. Segundo a Sociedade Brasileira de Infectologia, o infectologista é o médico especialista em diagnosticar doenças infecciosas que podem ser causadas por vírus, bactérias, fungos, entre outros microrganismos. O papel do infectologista é com o diagnóstico e com a prevenção para tratar pacientes com infecções provocadas por esses inimigos invisíveis. Seu principal objetivo é investigar, apresentar propostas de uma terapia adequada e prevenir processos infecciosos, assim como analisar o quadro clínico em questão.

É o termo técnico utilizado para a concentração de um vírus em um paciente infectado. Ela pode ser medida por exames que contam a quantidade de vírus presente em uma amostra de sangue. Normalmente, a quantidade de cópias de RNA viral presente em uma amostra de plasma sanguíneo é estimada após o teste de PCR quantitativo em tempo real.
POR QUE EXISTEM ASSINTOMÁTICOS
O que é especialmente intrigante é o motivo pelo qual esses dois grupos — transmissores

São pessoas com cargas virais muito altas, mas que ainda não apresentam sintomas. Devido ao alto índice de carga viral, esse grupo é considerado aquele com maior potencial de transmissão do vírus. De acordo com uma pesquisa do Núcleo em Ecologia e Desenvolvimento Sócio-Ambiental de Macaé (NUPEM), da UFRJ, essas pessoas representam cerca de 45% das transmissões. Ou seja, transmitem mais o vírus do que os sintomáticos e os assintomáticos. Segundo os estudiosos, isso acontece porque os pré-sintomáticos possuem as cargas virais altas e não percebem que estão com sintomas ou acreditam que não podem transmitir por não apresentarem sintomas.

É uma doença respiratória causada pelo vírus influenza tipo A São conhecidos 3 tipos de vírus da influenza: A, B e C Esses vírus são altamente transmissíveis e podem sofrer mutações (transformações em sua estrutura genética), sendo que o tipo A é o mais mutável Geralmente as epidemias e pandemias (situação da doença em vários países) estão associadas ao vírus do tipo A.